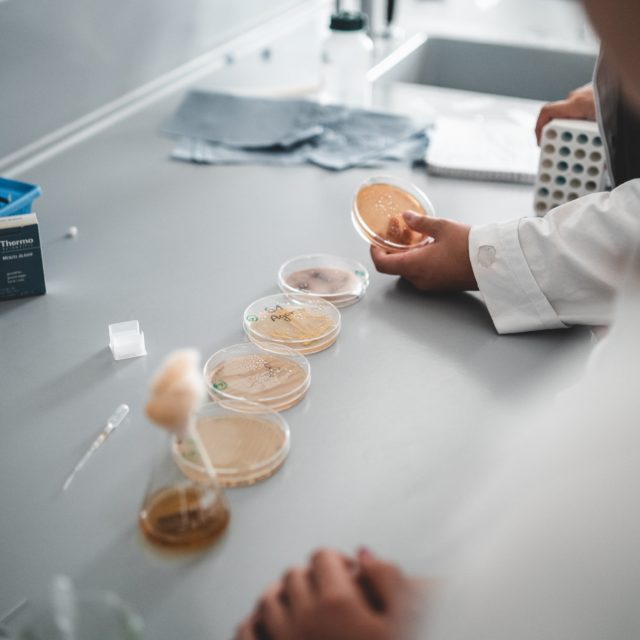

Schüler_innen der NMS 2 Wörgl und NMS Langkampfen an der Chemie-HTL Kramsach. Die Tiroler Tageszeitung war dabei und veröffentlichte diesen Beitrag:
Heute ist für die Schüler_innen der 3. Klasse der HTL Kramsach – Chemie und der Mittelschulen von Langkampfen und Wörgl ein außergewöhnlicher Tag: Zur Abwechslung lernen Schüler von Schülern und gemeinsam tauchen sie ein in die spannende Welt der Mikrobiologie.
Im Labor der HTL stehen verschiedene Experimentierstationen bereit, an denen nach Lust und Laune erste mikrobiologische Handgriffe geübt werden.

klasse!forschung unterstützt Peer-to-Peer Aktivitäten und möchte das Angebot im kommenden Jahr ausbauen: das Arbeiten mit und von von Schülern ist eine nachhaltige Lernerfahrung, macht Spaß, gibt praktische Einblicke in unterschiedlichste Schultypen und erleichtert so vielleicht die Wahl einer naturwissenschaftlichen Ausbildung.
Interessierte Schulen, die einen Workshop anbieten oder in Anspruch nehmen möchten, können sich unter office@klasse-forschung.at informieren.